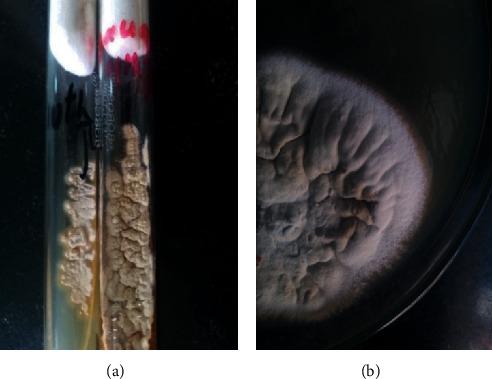
https://cdn.ncbi.nlm.nih.gov/pmc/blobs/e8fc/8249133/14961781e9db/CRIID2021-5527974.002.jpg

一名尼泊尔男孩的凯尔西蜂窝织炎:头皮肿胀的一个未被充分诊断的病因。
Kerion Celsi in a Nepalese Boy: An Underdiagnosed Cause of Scalp Swelling.
作者信息
Parajuli Ranjana, Shrestha Ashish Lal, Nayak Niranjan, Gokhale Shishir, Gautam Kundan, Subedi Shishir
机构信息
Department of Microbiology, Grande International Hospital, Dhapasi, Tokha Road, Kathmandu, Nepal.
Department of Pediatric Surgery, Grande International Hospital, Dhapasi, Tokha Road, Kathmandu, Nepal.
出版信息
Case Rep Infect Dis. 2021 Jun 24;2021:5527974. doi: 10.1155/2021/5527974. eCollection 2021.
Tinea capitis (TC) is an infection of the scalp and hair caused by a dermatophyte fungus. Typically caused by the zoophilic and geophilic species of and , it remains the commonest cutaneous fungal infection in children. A 9-year-old Nepalese boy was evaluated in outpatients for multiple boggy scalp lesions for two months. Suspecting a bacterial etiology, the lesions were excised and sent for cultures. While bacterial cultures failed to grow, endothrix spores were readily detected in potassium hydroxide preparation and histopathology. was identified by the phenotype method and later confirmed by matrix-assisted laser desorption ionization-time of flight (MALDI-TOF). Systemic antifungal therapy for 6 weeks along with local wound dressings resulted in complete recovery. At 2-year follow-up, focal alopecia was seen; however, no recurrence was noted.
头癣(TC)是一种由皮肤癣菌引起的头皮和头发感染。通常由亲动物性和亲土性的 和 物种引起,它仍然是儿童中最常见的皮肤真菌感染。一名9岁的尼泊尔男孩因头皮出现多个软肿性病变两个月而在门诊接受评估。怀疑是细菌病因,对病变进行了切除并送去培养。虽然细菌培养未生长,但在氢氧化钾制剂和组织病理学检查中很容易检测到发内孢子。通过表型方法鉴定出 ,后来通过基质辅助激光解吸电离飞行时间(MALDI-TOF)得到证实。进行了6周的全身抗真菌治疗并结合局部伤口敷料,结果完全康复。在2年的随访中,出现了局部脱发;然而,未观察到复发。